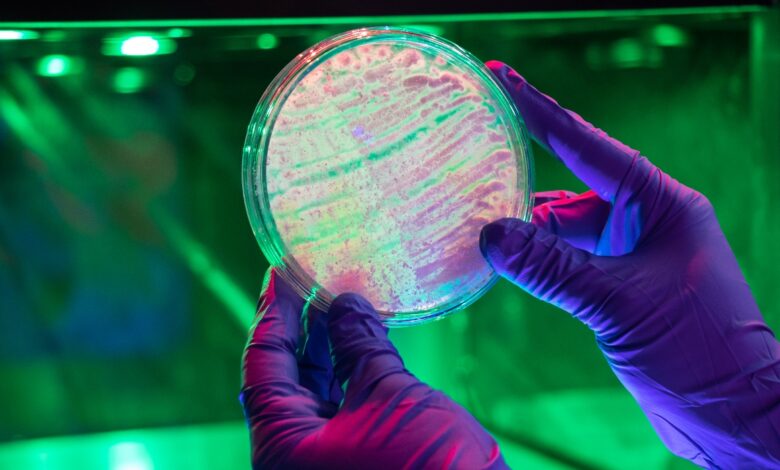

Agrosavia reconoce la grave situación fiscal por la que atraviesa el país y las acciones que se han tomado desde el Ministerio de Hacienda
17 de febrero, 2025.
AGROSAVIA, la institución pública responsable de la investigación agropecuaria en Colombia reconoce la grave situación fiscal por la que atraviesa el país y las acciones que se han tomado desde el Ministerio de Hacienda para garantizar la sostenibilidad económica y el cumplimiento de la regla fiscal.
Para la presente vigencia, el presupuesto destinado a esta Corporación tuvo una reducción drástica del 27,5 % pasando de $299.325 millones en el 2024 a $216.754 millones en el 2025. En esa reducción se incluyen $10.000 millones que se encuentran aplazados y que solicitamos se siga considerando como una medida temporal y no un recorte definitivo; de esta manera lograremos disminuir el impacto sobre la institución.
La Corporación se permite suministrar la información de los recursos del presupuesto general de la nación transferidos a partir del año 2015. Se recomienda utilizar en los análisis la serie a precios constantes, es decir, el valor real del presupuesto recibido después de descontar el efecto que tiene la inflación, con el objeto de que las cifras sean comparables.

Como se refleja en el gráfico adjunto, el presupuesto 2025 asignado a AGROSAVIA es el más bajo desde que entró en vigencia la Ley 1731 de 2014, a través de la cual se crea la transferencia de recursos para el cumplimiento de la misión de la Corporación.
Dada la necesidad de continuar aportando a los objetivos del Plan Nacional de Desarrollo (Colombia potencia mundial de la vida), AGROSAVIA ha estado en trabajo permanente con el Ministerio de Agricultura y Desarrollo Rural y acordó, como siempre se ha hecho, el Marco de Metas y Resultados que orientará las actividades de la Corporación en el año 2025.
Como lo ha señalado el Ministerio de Agricultura en su comunicado, en la actualidad el proyecto de resolución que ordena la transferencia de recursos del Ministerio a AGROSAVIA para su operación se encuentra en consulta pública en el portal Sucop.gov.co para observaciones de la comunidad.Como se ha realizado en el pasado, una vez esté firmada la resolución se activará el pago de los salarios pendientes.
AGROSAVIA ha sido informada de la realización de marchas previstas para el próximo martes 18 de febrero organizadas por las y los trabajadores en todo el país. Respetamos el derecho a manifestarse de manera pacífica privilegiando el respeto a las instituciones que nos ha caracterizado siempre como equipo.
AGROSAVIA ha tomado desde hace una década las medidas necesarias para garantizar la continuidad de su equipo de investigación y de apoyo a través de contratos laborales formales a término indefinido. La entidad es ejemplo en el Programa de Formalización del Empleo Público promovido por el actual gobierno; a cierre de diciembre 2024 se contaba con una planta de 2.020 personas de las cuales el 90 % estaban vinculadas mediante contrato a término indefinido. Dada la magnitud del recorte es necesario reducir el tamaño de la planta de personal garantizando que se paguen las indemnizaciones previstas en la Ley por la terminación sin justa causa.
Tan pronto se informó a nuestra institución del recorte se empezaron a tomar las medidas necesarias para enfrentar esta crisis. La totalidad del equipo de AGROSAVIA se dedicó a identificar los gastos que pudieran ser principalmente aplazados y otros eliminados con el fin de superar este momento tan desafiante que pone en riesgo la viabilidad de la Corporación. Como resultado de este ejercicio a la fecha se han tomado medidas a través de las cuales se recortan los gastos de operación en $44.000 millones. Dichas medidas serán presentadas a la Junta Directiva de AGROSAVIA en los próximos días para continuar analizando esta situación y obtener su orientación y la eventual aprobación de medidas adicionales, buscando que el impacto en la reducción del equipo humano sea el menor posible.
Conscientes de la necesidad de diversificar las fuentes de financiamiento de AGROSAVIA, continuaremos gestionando recursos diferentes a la transferencia del presupuesto general de la nación para responder a las necesidades de las y los productores del campo. Como resultado de esta gestión exitosa, la Corporación ha movilizado en el último trienio recursos superiores a los $196.000 millones. Por supuesto, para mantener este nivel de logros será necesario contar con nuestro equipo científico.
Los recursos que recibe AGROSAVIA generan resultados concretos y pertinentes. A través de la metodología internacional del Balance Social que la institución aplica desde hace siete años, AGROSAVIA mide el impacto que genera en el país. Gracias al trabajo que realizamos en los territorios con las comunidades y con nuestros aliados, la Corporación le retorna a la sociedad 3,5 veces más de lo que recibe para el desarrollo de su misión.
Seguiremos enfocados en la gestión diligente y transparente de los recursos. En los años 2022 y 2023 tuvimos un nivel de ejecución de los recursos asignados del 99 %. El año 2024 logramos una ejecución del 92,6 % dejando recursos disponibles para garantizar la continuidad de los proyectos de investigación sin poner en riesgo temas tan cruciales como la conservación de los bancos de germoplasma de la nación.
Los 46 proyectos que se desarrollan en el Catatumbo, Cauca, Chocó, Tumaco y Putumayo contarán con prioridad en la asignación de los recursos disponibles dadas las actuales condiciones que se están presentando en esas zonas del país.
En el 2024 realizamos 2.447 encuentros en 413 municipios para compartir e intercambiar conocimientos con la participación de 62.710 asistentes mayoritariamente productoras y productores, mujeres campesinas y jóvenes rurales. Nuestros 13 centros de investigación en todo el país seguirán con las puertas abiertas para mostrar los avances de nuestros proyectos a las comunidades del campo y al público en general, y haremos lo que esté a nuestro alcance para mantener estos puntos de encuentro y diálogo con ellos.
A los usuarios de nuestros servicios de análisis de suelos y de leche les informamos que continuaremos prestando el servicio y dada la criticidad de esa información no habrá afectación y les responderemos en los tiempos ya establecidos.
Con la firma de la resolución, estarían garantizados los recursos necesarios para salvaguardar los bancos de germoplasma de la nación donde se conserva la diversidad genética de nuestro país: Banco animal (10 razas criollas), vegetal (275 especies conservadas a través de 30.000 accesiones de semillas, 1.200 accesiones de especies con multiplicación clonal y 4.000 accesiones en campo)
y de microorganismos (2.253 accesiones).
Nos permitimos informar a los financiadores internacionales y nacionales que los 271 proyectos que estamos ejecutando conjuntamente seguirán su plan de actividades de la mejor manera como hasta ahora se ha hecho.
Informamos a la opinión pública que se suspendieron los 22 procesos de selección y contratación que se encontraban en desarrollo. Agradecemos a los cerca de 1.000 candidatos que concursaron para cubrir esas vacantes y les agradecemos su interés de pertenecer a AGROSAVIA.
Esperamos pronto solucionar esta situación con el apoyo del gobierno nacional para continuar enfocados en nuestro propósito superior: “Transformamos de manera sostenible el sector agropecuario colombiano con el poder del conocimiento para mejorar la vida de productores y consumidores”.





